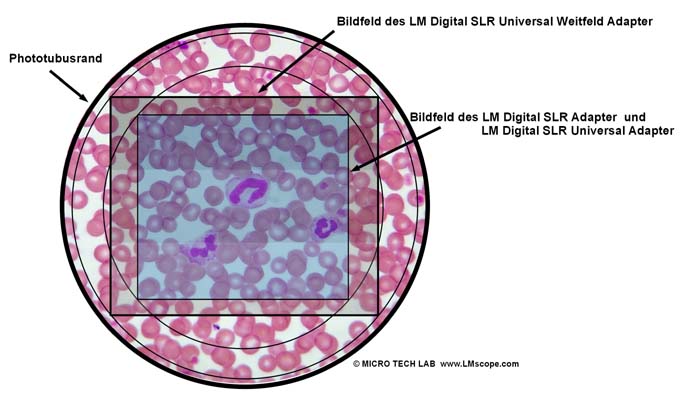
Bildfeld Weitfeldadapter, APS-C Sensor

+43-664-7926425
+43-664-7926425 

LM digital SLR Weitfeld Adapter: Fokussierbar und mit größerem Bildfeld
Die Optimierung unseres bewährten Tubus Mikroskop Adapters für Okulartuben mit 30 mm Innendurchmesser!
Ab sofort gibt es unseren LM digital Tubus Adapter wie auch unseren LM digital C-Mount Adapter in der erweiterten Version. Der neue LM digital Universal Weitfeld Adapter hat eine Optik (entspricht dem Sehfeld eines 10x Okulars) und ein um 25% größeres Bildfeld als unser Standard LM Adapter und ist fokussierbar!
Der LM digital Weitfeld Adapter ist fokussierbar und besitzt eine planachromatische Präzisions-Optik. Er nutzt das gesamte Bildfeld des Mikroskops aus, auch die Randbereiche des Bilds werden auf den Fotos abgebildet. Wir empfehlen den LM Digital SLR Weitfeld Adapter nur bei hochwertigen Mikroskopen mit voll auskorrigierten Mikroskopobjektiven (wie z.B. unendlich korrigierte Planachromate, Planflourite, Planapochromate etc.) zu verwenden. Bei weniger hochwertigen Mikroskopobjektiven (ohne die Bezeichnung "plan") gelingt es nicht, das Bildzentrum und die Randbereiche gleichzeitig scharf abzubilden, da diese Objektive meist eine ausgeprägte Bildwölbung aufweisen. Bei Betrachtung mit dem Auge durch das Okular scheint das Bild jedoch scharf zu sein, weil das menschliche Auge durch Akkomodation Unschärfen ausgleicht.
In der Produktsuche (Online-Konfigurator) finden Sie diesen Artikel unter "Erweiterte Adapterlösung mit fokussierbaren LM Digital SLR Adapter und größerem Bildfeld".
Neue LM Digital-Adapter für: Sony Alpha 9 III / Nikon Z9 / Nikon Z8 / Sony Alpha 7R V / Sony Alpha 1 II / Sony Alpha 1 / Sony Alpha 9 II (ILCE-9M2) / Sony FX3 Cinema Line / Sony Alpha 9 / Nikon D6 / Canon EOS R3 / Canon EOS R6 Mark II / Canon EOS R8 / Sony Alpha 7R IV / Canon EOS R5 II / Nikon Z6III / Canon EOS R5 / Sony Alpha 7S II / Sony Alpha 7S III / Sony Alpha 7R III / Canon EOS R6 / Nikon Z6 / Nikon Z6II / Sony Alpha 7R II / Nikon Z7 / Nikon Z7II / Canon EOS R / Canon EOS Ra (Astro) / Nikon Z5 / Sony Alpha 7C / Canon EOS RP / Sony Alpha 7S / Canon EOS R7 / Leica SL2-S / Canon EOS R10 / Nikon Z50 II / Canon EOS 1D X Mark III / Nikon Z50 / Nikon Z30 / Nikon Z fc / Nikon D850 /